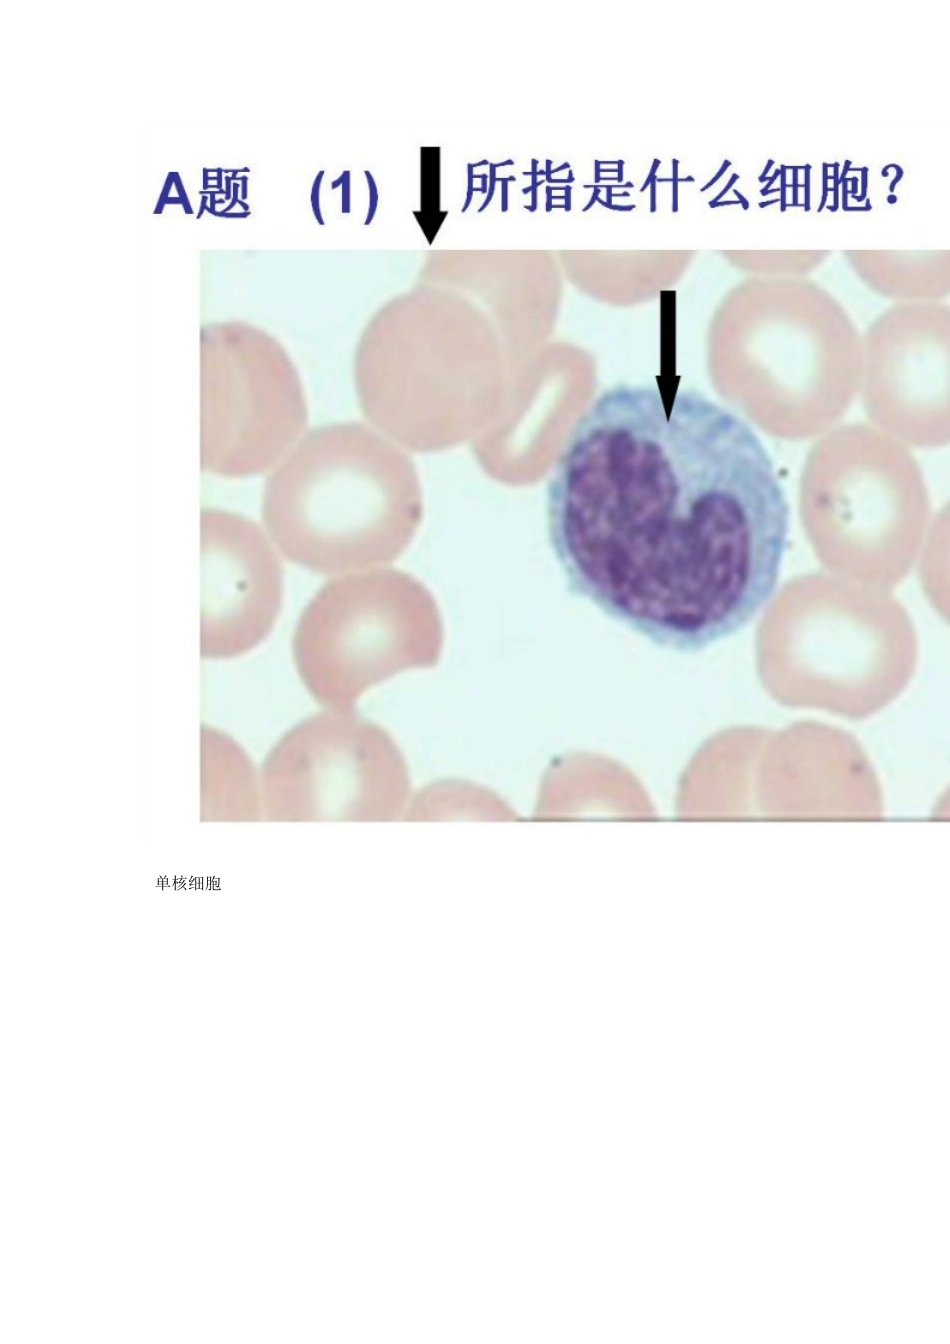

1、本站所有内容均由用户上传,如文档内容存在违规,或者侵犯商业秘密、侵犯著作权等,请联系我们督促用户删除。
2、当您付费下载文档后,并不意味着购买了版权,版权任归原作者所有,文档只能用于自身研究参考使用,不得用于商业用途。
3、本站不对文档的完整性、权威性及其观点立场正确性做任何保证或承诺!文档内容仅供研究参考,付费前请自行鉴别。
电脑上下载的文档不知道保存在哪里?
使用键盘组合键(ctrl + j),就能打开浏览器的下载列表,查看文档下载进度和保存位置。
文档是由不同用户整理和上传,上传的时候是什么格式和内容,下载之后也不会变。建议您先查看一下文档内容和格式,是否符合自己的要求。









